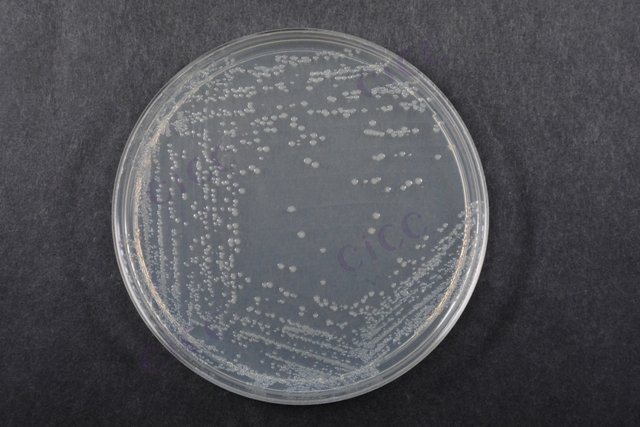
大肠埃希氏菌O157 Escherichia coli O157:H7 CICC 10907 Escherichia coli O157:H7

大肠埃希氏菌O157 Escherichia coli O157:H7 CICC 10907 Escherichia coli O157:H7
-
大肠埃希氏菌 Escherichia coli O157:H7 CICC 25013 Escherichia coli O157:H7
CICC 25013 | 见证书
-
肠道出血性大肠埃希氏菌 Escherichia coli EHEC O157:H7 CICC 21530 Escherichia coli EHEC O157:H7
CICC 21530 | 见证书
-
大肠埃希氏菌O157:H7DNA标准品 Escherichia coli O157:H7 DNA standard
BNCC380032 | 冻存管
-
Escherichia coli O157:H7
BNCC379666 | 冻干粉;斜面;菌液;平板
-
Escherichia coli O157:H7
CICC 25276 | 见证书
-
Escherichia coli O157:H7
BNCC186579 | 冻干粉;斜面;菌液;平板
-
大肠埃希菌 Escherichia coli (O157:H7) ATCC 43888 KWIK-STIK 6PK Escherichia coli (O157:H7) derived from ATCC® 43888™
0795K | 6支/盒

说明书下载: 菌种说明书 打管说明书
您正在浏览的产品:大肠埃希氏菌O157 Escherichia coli O157:H7 CICC 10907
手机版:大肠埃希氏菌O157 Escherichia coli O157:H7 CICC 10907
本公司销售的所有产品仅供实验科研使用,不用于人体及临床诊断。
1. 增菌培养:使用改良EC肉汤(mEC+n)进行选择性增菌(36℃±1℃,18-24小时)
2. 分离培养:采用CT-SMAC琼脂平板分离可疑菌落(36℃±1℃,18-24小时)
3. 生化鉴定:通过三糖铁琼脂(TSI)等生化反应初步筛选
4. 血清学鉴定:O157和H7特异性抗血清凝集试验[3][5]
2. 阴性对照:采用非目标菌株(如ATCC25922)排除交叉反应
3. 空白对照:包含培养基和试剂的无菌对照,确保无污染[8][9]
2. 平板分离:取增菌液划线CT-SMAC琼脂,观察典型菌落特征
3. 生化验证:TSI斜面反应(底层黄色/斜面红色,H₂S阴性)
4. 免疫学确认:O157多价抗血清凝集试验,H7鞭毛抗原检测[2][3][5]
2. CT-SMAC培养基需验证其选择性,避免杂菌干扰
3. 血清凝集试验需同时进行自凝对照,排除假阳性
4. 对山梨醇阴性菌落需进一步验证,避免漏检变异株[3][5][8]
以上信息仅供参考,请以相应标准的原文为准!